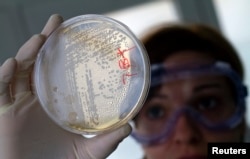
Pekerja laboratorium sedang mencari bakteri E.coli dalam sel-sel sayuran di dalam cawan petri..

Data baru dari 22 negara dengan pendapatan tinggi hingga rendah menunjukkan resistansi antibiotik terhadap sejumlah infeksi bakteri serius semakin berkembang dalam tingkat yang mengkhawatirkan. Organisasi Kesehatan Dunia (WHO) melakukan survei terhadap 1,5 juta orang dengan dugaan infeksi bakteri pada Maret 2016-Juli 2017.
Survei itu, yang pertama untuk survei jenis ini, sangat vital untuk memperbaiki dan memahami jangkauan resistansi antimikroba di dunia. Juru bicara WHO, Christian Lindmeier, mengatakan kepada VOA, penemuan itu memunculkan banyak tanda-tanda peringatan.
"Data yang diberikan oleh negara-negara itu menunjukkan bahwa beberapa bakteri yang paling biasa, yang paling sering dilaporkan bakteri resistansi, kami menemukan tingkat resistansinya kadang bisa mencapai 65 persen hingga 82 persen, tergantung jenis bakterinya. Dan..ini data yang sangat mengkhawatirkan," kata dia.
Bakteri resistansi terhadap antibiotik yang paling sering dilaporkan, termasuk infeksi bakteri e-coli, infeksi bakteri staphylococcus, pneumonia dan salmonella. WHO mendorong semua negara untuk membuat sistem pengamatan yang bagus untuk mendeteksi resistansi obat. Sistem ini akan memberikan informasi yang dibutuhkan untuk mengatasi ancaman-ancaman terbesar bagi kesehatan masyarakat dunia.
Jika resistansi obat tidak berhasil diatasi, Lindmeier memperingatkan dunia bisa kembali ke masa-masa berbahaya sebelum penisilin ditemukan.
"Infeksi biasa, luka gores, operasi ringan, bisa tiba-tiba menjadi situasi yang paling berbahaya dan mengancam jiwa karena infeksi-infeksi tersebut akan terbukti resistansi terhadap obat-obatan," kata dia. "Pengobatan kanker, misalnya, akan menjadi tantangan besar selain kanker itu sendiri karena sistem kekebalan tubuh yang sudah rendah tidak bisa ditingkatkan dengan antibiotik. Infeksi apa pun akan menimbulkan risiko tambahan."
Lindmeier mengatakan beberapa negara menanggapi peringatan-peringatan ini dengan baik. Misalnya, dia mencatat, Kenya meningkatkan sistem resistansi antimikroba nasional, Tunisia sekarang mengumpulkan data nasional resistansi obat, dan Korea memperkuat sistem pengawasannya. [fw/au]